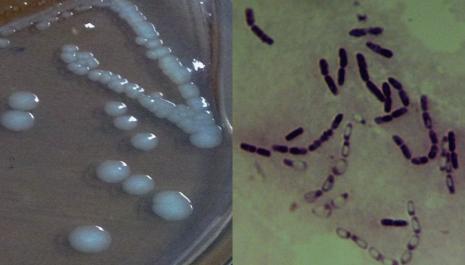

Š·ųĻL-1▓╗═¼ĮėĘN┴┐ī”(du©¼)─ŻöMÅU╦«(25mg·L-1)ūŅ╝č╠Ä└Ēą¦╣¹
ųąć°(gu©«)╬█╦«╠Ä└Ē╣ż│╠ŠW(w©Żng) Ģr(sh©¬)ķgŻ║2016-1-23 9:10:08
╬█╦«╠Ä└Ē╝╝ąg(sh©┤) | ģRŠ█╚½Ū“Łh(hu©ón)▒Ż┴”┴┐Ż¼ĮĄĄ═Ų¾śI(y©©)ų╬╬█│╔▒Š
ĪĪĪĪ1 ę²čį
ĪĪĪĪ┬╚▒ĮŅÉ╗»║Ž╬’ū„×ķ▐r(n©«ng)╦Ä╝░╚Š┴Ž║Ž│╔ųąķg¾wĪóŪÕŽ┤╚▄ä®╝░├ōų¼ä®│╔ĘųÅVĘ║╩╣ė├.ūį╚╗Įń╬ó╔·╬’╚▒Ę”ĮĄĮŌ┤╦ŅÉ╗»║Ž╬’Ą─├Ė╗“├ĖŽĄĮy(t©»ng)Ż¼║▄ļy▀M(j©¼n)ąą╔·╬’╠Ä└ĒŻ¼╬ó╔·╬’ĮĄĮŌŠ·Ą─║Y▀x║═ĮĄĮŌąį─▄蹊┐╩ŪīŹ(sh©¬)¼F(xi©żn)╔·╬’ĮĄĮŌ│ųŠ├ąįėąÖC(j©®)╬█╚Š╬’Ą─ĻP(gu©Īn)µI.1Ż¼2Ż¼3Ż¼4-TeCBį┌GB 6944Ī¬2005ųą╬ŻļU(xi©Żn)ś╦(bi©Īo)ėø×ķ14(ėąČŠ╬’ŲĘ)Ż¼╩Ūę╗ĘNĄõą═Ą─┬╚▒ĮŅÉ╗»║Ž╬’Ż¼ī”(du©¼)╚╦¾wĄ─Ųż─wĪó╔Ž║¶╬³Ą└║═š│─żėą┤╠╝żū„ė├Ż¼┐╔į┌╚╦¾wā╚(n©©i)Ęe└█.─┐Ū░╦─┬╚▒ĮĄ─蹊┐ų„ę¬ć·└@Ųõ╬’└Ē╠žąį║═ČŠąį.╦─┬╚▒ĮĄ─Š¦¾wĮY(ji©”)śŗ(g©░u)║═╗ņ║ŽŠ¦¾wĮY(ji©”)śŗ(g©░u)Ż¼į┌╦«║═┐šÜŌų«ķgĄ─é„┘|(zh©¼)ū„ė├Ż¼│┴Ęe╬’║═æęĖĪ╬’ī”(du©¼)1Ż¼2Ż¼3Ż¼4-TeCBĄ─╬³ĖĮū„ė├Ż¼1Ż¼2Ż¼3Ż¼4-TeCBī”(du©¼)įą╩¾Ė╬║═╔·ų│┬╩ė░ĒæĄ╚Š∙ėąÅVĘ║蹊┐.ī”(du©¼)ė┌Ą═Ęųūė┬╚▒ĮŅÉ╗»║Ž╬’╝░╩ūŽ╚▒╗Ž▐ųŲ╩╣ė├Ą─┴∙┬╚▒Į╬ó╔·╬’ĮĄĮŌęčėąę╗ą®ł¾(b©żo)Ą└.Ą½ĻP(gu©Īn)ė┌TeCBsĄ─╬ó╔·╬’ĮĄĮŌ蹊┐ģs§rėął¾(b©żo)Ą└.蹊┐░l(f©Ī)¼F(xi©żn)Ż¼╬Õ┬╚▒ĮĪó┴∙┬╚▒Įį┌ĮĄĮŌ▀^(gu©░)│╠ųą═∙═∙┤µį┌1Ż¼2Ż¼3Ż¼4-TeCBųąķg«a(ch©Żn)╬’Ż¼▀@▒Ē├„1Ż¼2Ż¼3Ż¼4-TeCBĄ─ĮĄĮŌ╩ŪĖ▀┬╚▒Į╗»║Ž╬’ĮĄĮŌĄ─ĻP(gu©Īn)µI▓Į¾E.▒Š╬─Å──│┬╚▒Įįćä®ÅSĄ─═┴╚└ųą╚ĪśėŻ¼║Y▀x│÷ę╗ųĻęį1Ż¼2Ż¼3Ż¼4-TeCBū„×ķ╬©ę╗╠╝į┤Ą─ĮĄĮŌŠ·Ż¼▓ó蹊┐┴╦įōŠ·ųĻī”(du©¼)1Ż¼2Ż¼3Ż¼4-TeCBĮĄĮŌą¦╣¹╝░ĮĄĮŌ═ŠÅĮŻ¼×ķ╬ó╔·╬’ĮĄĮŌ┬╚▒ĮŅÉ╬’┘|(zh©¼)╠ß╣®īŹ(sh©¬)“×(y©żn)ę└ō■(j©┤).
ĪĪĪĪ2 ▓─┴Ž║═ĘĮĘ©
ĪĪĪĪ2.1 įŁ┴Ž┼cįćä®
ĪĪĪĪ╦∙ė├═┴śė╚ĪūįÅV¢|─│╗»īW(xu©”)įćä®ÅSķL(zh©Żng)Ų┌╩▄╦─┬╚▒Į╬█╚ŠĄ─═┴╚└ū„×ķŠ·ųĻĘųļxį┤.
ĪĪĪĪ╗»īW(xu©”)įć䮯║1Ż¼2Ż¼3Ż¼4-TeCBĪó▒¹═¬Īóš²╝║═ķĄ╚įć䮊∙×ķā×(y©Łu)╝ē(j©¬)╝ā.┼ÓB(y©Żng)╗∙Ż║│ŻęÄ(gu©®)┼Ż╚ŌĖÓĄ░░ūļ╦;¤o(w©▓)ÖC(j©®)¹}┼ÓB(y©Żng)╗∙(ĮMĘų▓╗║¼Cl-)Š∙×ķ│ŻęÄ(gu©®)┼õĘĮ(įć䮊∙×ķĘų╬÷╝ā)
ĪĪĪĪ2.2 ų„ę¬īŹ(sh©¬)“×(y©żn)āxŲ„
ĪĪĪĪ╔·╗»┼ÓB(y©Żng)Žõ;║Ń£ž╦«įĪš±╩ÄŲ„;│¼ā¶╣żū„┼_(t©ói);Ė▀╦┘ļxą─ÖC(j©®);CODŽ¹ĮŌāx;ļxūė╔½ūVāx;Ė▀ą¦ę║ŽÓ╔½ūV;ÜŌŽÓ╔½ūV-┘|(zh©¼)ūV┬ō(li©ón)ė├āx.
ĪĪĪĪ2.3 Š·ĘNĖ╗╝»║═Ęųļx╝ā╗»
ĪĪĪĪ╚Ī1 g═┴╚└ė┌100 mLš¶s╦« ųąŻ¼ōu┤▓š±╩Ä15 minŻ¼śėŲĘŽĪßī║¾ų▒Įė═┐▓╝į┌100 mg Īż L-1 1Ż¼2Ż¼3Ż¼4-TeCBĄ─¤o(w©▓)ÖC(j©®)¹}┼ÓB(y©Żng)╗∙.┤²ķL(zh©Żng)│÷Š·┬õ║¾Ż¼╠¶╚Īå╬Š·┬õį┌Ė▀ØŌČ╚(250 mg Īż L-1)1Ż¼2Ż¼3Ż¼4-TeCBĄ─ę║¾w┼ÓB(y©Żng)╗∙±Z╗».Įø(j©®ng)▀^(gu©░)5~7 d±Z╗»║¾(Č©Ų┌Ė³ōQ┼ÓB(y©Żng)ę║)Ż¼╚Ī1~2 mLŠ·ę║═┐▓╝ė┌1Ż¼2Ż¼3Ż¼4-TeCB×ķ╬©ę╗╠╝į┤Ą─¤o(w©▓)ÖC(j©®)¹}ŲĮ░ÕŻ¼30 Īµ║Ń£ž┼ÓB(y©Żng)Ż¼╠¶▀x╔·ķL(zh©Żng)▌^┐ņĄ─å╬Š·┬õĮėĘNĄĮ100 mg Īż L-1 1Ż¼2Ż¼3Ż¼4-TeCBę║¾w¤o(w©▓)ÖC(j©®)¹}┼ÓB(y©Żng)╗∙ųąš±╩Ä┼ÓB(y©Żng);ČÓ┤╬ŲĮ░ÕäØŠĆĘųļxŻ¼½@Ą├å╬Š·┬õ.
ĪĪĪĪ2.4 Š·ųĻą╬æB(t©żi)ė^▓ņĪó╔·ķL(zh©Żng)Ū·ŠĆ╝░16S rDNAą“┴ąĘų╬÷
ĪĪĪĪīó╝ā╗»║¾Ą─Š·ųĻį┌╣╠¾w┼ÓB(y©Żng)╗∙╔Ž▀M(j©¼n)ąąäØŠĆ┼ÓB(y©Żng)Ż¼┤²ķL(zh©Żng)│÷å╬éĆ(g©©)Š·┬õ║¾▀M(j©¼n)ąąą╬æB(t©żi)ė^▓ņ;ī”(du©¼)Š·ųĻ▀M(j©¼n)ąąĖ’╠m╩Ž╚Š╔½ė^▓ņ;ė├OD600╠Ä£y(c©©)Č©╔·ķL(zh©Żng)Ū·ŠĆ.PCR«a(ch©Żn)╬’Įø(j©®ng)─²─zļŖėŠĘų╬÷Öz£y(c©©)║¾īóPCR«a(ch©Żn)╬’╦═ų┴ÅVų▌╣żśI(y©©)╬ó╔·╬’Öz£y(c©©)ųąą─╗ž╩š▓ó£y(c©©)ą“.
ĪĪĪĪ2.5 Š·ųĻī”(du©¼)1Ż¼2Ż¼3Ż¼4-╦─┬╚▒ĮĮĄĮŌą¦╣¹Ą─蹊┐
ĪĪĪĪīŹ(sh©¬)“×(y©żn)╦∙ė├ÅU╦«×ķ25 mg Īż L-1 1Ż¼2Ż¼3Ż¼4-TeCB─ŻöMÅU╦«Ż¼pH 7.
ĪĪĪĪ╚Ī200 mL¤o(w©▓)ÖC(j©®)¹}┼ÓB(y©Żng)╗∙ų├ė┌500 mLÕFą╬Ų┐ųąŻ¼Įø(j©®ng)Ė▀£ž£ńŠ·║¾Ż¼┼õų├│╔25 mg Īż L-1Ą──ŻöMÅU╦«Ż¼Ęųäe╝ė╚ļ2%Īó3%Īó5%Ą─Š·æęę║.30 ĪµŻ¼110 r Īż min-1.ĮėĘN║¾├┐╠ņČ©Ģr(sh©¬)╚Īśė.Ęųäe£y(c©©)Č©─ŻöM┼ÓB(y©Żng)ę║ųąCODĪóCl-ØŌČ╚Īó1Ż¼2Ż¼3Ż¼4-TeCBØŌČ╚Ą─ė░ĒæŻ¼▀B└m(x©┤)£y(c©©)Č©7 d.├┐ĮM3éĆ(g©©)ŲĮąą.
ĪĪĪĪ1)COD£y(c©©)Č©Ż║┐ņ╦┘Ž¹ĮŌĘų╣Ō╣ŌČ╚Ę©.
ĪĪĪĪ2)┬╚ļxūėØŌČ╚£y(c©©)Č©Ż║śėŲĘ£y(c©©)Č©Ū░Ż¼śėŲĘĮø(j©®ng)▀^(gu©░)0.22 ”╠m ╬ó┐ū▀^(gu©░)×V─żŻ¼ė├ļxūė╔½ūVāx£y(c©©)Č©┬╚ļxūėØŌČ╚.
ĪĪĪĪ3)1Ż¼2Ż¼3Ż¼4-TeCBØŌČ╚£y(c©©)Č©Ż║ė├Ė▀ą¦ę║ŽÓ£y(c©©)Č©.Ū░╠Ä└ĒŻ║ÅU╦«Įø(j©®ng)0.22 ”╠m╬ó┐ū▀^(gu©░)×V─ż▀^(gu©░)×VŻ¼£y(c©©)Č©▀^(gu©░)×Vę║ųą1Ż¼2Ż¼3Ż¼4-TeCB.£y(c©©)Č©Śl╝■Ż║TH 1015ą═C18╦ßąįų∙;┴„äė(d©░ng)ŽÓ×ķ╝ū┤╝┼c╦«░┤85:15¾wĘe▒╚╗ņ║Ž;ų∙£ž25 Īµ;▀M(j©¼n)śė¾wĘe10 ”╠L;ļp▓©ķL(zh©Żng)Öz£y(c©©)Ż║▓©ķL(zh©Żng)×ķ214 nmĪó216 nm.
ĪĪĪĪ2.6 ĮĄĮŌ╠žąįĘų╬÷
ĪĪĪĪ▓╗═¼╠Ä└ĒĢr(sh©¬)ķgĄ─ÅU╦«Įø(j©®ng)0.22 ”╠m ╬ó┐ū▀^(gu©░)×V─ż▀^(gu©░)×VŻ¼┤ĄÆ▀▓Č╝»║¾Ż¼└¹ė├ÜŌŽÓ┘|(zh©¼)ūV┬ō(li©ón)ė├āx(GC-MS)£y(c©©)Č©┬╚▒ĮĮĄĮŌŪķør╝░«a(ch©Żn)╬’Ęų╬÷.┤ĄÆ▀▓Č╝»Śl╝■Ż║┤Ą├ōĢr(sh©¬)ķgŻ║11 min;┤Ą├ō£žČ╚Ż║350 Īµ;ĮŌ╬÷£žČ╚Ż║225 Īµ;ĮŌ╬÷Ģr(sh©¬)ķgŻ║6 min;║µ┐Š£žČ╚Ż║235 Īµ;║µ┐ŠĢr(sh©¬)ķgŻ║5 min.ūó╚ļśėŲĘ5 mL.╔½ūVŚl╝■Ż║Öz£y(c©©)Ų„£žČ╚Ż║300 Īµ;▀M(j©¼n)śė┐┌£žČ╚Ż║260 Īµ;ų∙Žõ£žČ╚Ż║Ų╩╝60 ĪµŻ¼▒Ż│ų2ĘųńŖŻ¼ęį5 Īµ Īż min-1Ą─╦┘Č╚╔²£žų┴160 ĪµŻ¼▒Ż│ų2 min.Ęų┴„▒╚Ż║10 Ī├ 1.
ĪĪĪĪ3 ĮY(ji©”)╣¹┼cĘų╬÷
ĪĪĪĪ3.1 Š·ųĻ╔·└Ē╔·╗»╠žąįĪó16S rDNAą“┴ąĘų╬÷╝░╔·ķL(zh©Żng)Ū·ŠĆ
ĪĪĪĪęį1Ż¼2Ż¼3Ż¼4-TeCB×ķ╬©ę╗╠╝į┤Ė╗╝»ĪóĘųļxĪó±Z╗»╬ó╔·╬’Ż¼║Y▀x│÷ę╗ųĻį┌╣╠¾w┼ÓB(y©Żng)╗∙╔Ž─▄┐ņ╦┘╔·ķL(zh©Żng)Ą─Š·ųĻŻ¼├³├¹×ķL(zh©Żng)-1╠¢(h©żo)Š·.Š·┬õ▒Ē├µłA╗¼Ż¼▓╗═Ė├„Ż¼│╩░ū╔½╗“╬ó³S╔½.Š·ųĻ×ķČ╠ŚUĀŅŻ¼¤o(w©▓)▒▐├½Ż¼─▄▀\(y©┤n)äė(d©░ng)Ż¼─▄«a(ch©Żn)╔·ųą╔·č┐µ▀.Š·ųĻĖ’╠m╩Ž╚Š╔½ĮY(ji©”)╣¹×ķĻ¢(y©óng)ąįŠ·(G+)Ż¼╚ńłD 1╦∙╩Š.į┌┤╦╗∙ĄA(ch©│)╔ŽŻ¼ī”(du©¼)L-1╠¢(h©żo)Š·Ą─16SrDNA╗∙ę“ŽĄ┴ą▀\(y©┤n)ė├Basics BLAST▄ø╝■Ęų╬÷Ż¼║═Genbank▒╚ī”(du©¼)Ż¼L-1Š·ITSą“┴ą┼cBacillus subtilis AF0907(┐▌▓▌č┐µ▀ŚUŠ·)║═Bacillus carboniphilus JCM9731Š▀ėąūŅĖ▀Ą─═¼į┤ąįŻ¼Š∙▀_(d©ó)ĄĮ98.5%ęį╔Ž.ĮY(ji©”)║Ž╔·└Ē╔·╗»╠žąįŻ¼│§▓ĮĶbČ©įōŠ·ųĻ×ķ┐▌▓▌č┐µ▀ŚUŠ·.×ķ┴╦ĮŌŠ·ųĻ╔·ķL(zh©Żng)╠ž³c(di©Żn)Ż¼ī”(du©¼)L-1╠¢(h©żo)Š·▀M(j©¼n)ąą╔·ķL(zh©Żng)Ū·ŠĆĄ─£y(c©©)Č©Ż¼ęŖ(ji©żn)łD 2.
łD1 Š·ųĻ L-1 Ą─Š·┬õą╬æB(t©żi)║═Ė’╠m╩Ž╚Š╔½ 
łD2 Š·ųĻ L-1 Ą─╔·ķL(zh©Żng)Ū·ŠĆ
ĪĪĪĪÅ─łD 2ųą┐╔ęŖ(ji©żn)įōŠ·ųĻį┌0~3 h╔·ķL(zh©Żng)▌^┬²Ż¼5 h║¾čĖ╦┘▀M(j©¼n)╚ļ╔·ķL(zh©Żng)Ų┌Ż¼▒Ē├„įōŠ·ųĻØōĘ³Ų┌▌^Č╠─▄ē“┐ņ╦┘▀mæ¬(y©®ng)╔·ķL(zh©Żng)Łh(hu©ón)Š│Ż¼▀M(j©¼n)╚ļī”(du©¼)öĄ(sh©┤)╔·ķL(zh©Żng)Ų┌.12~34 hįōŠ·ųĻ╔·ķL(zh©Żng)£p┬²Ż¼▀M(j©¼n)╚ļĘĆ(w©¦n)Č©Ų┌Ż¼ų▒ĄĮ30 h║¾įōŠ·ųĻę╗ų▒╠Äė┌ĘĆ(w©¦n)Č©Ų┌Ż¼▒Ē├„įōŠ·ųĻ╔·ķL(zh©Żng)┤·ųxĘĆ(w©¦n)Č©Ų┌ķL(zh©Żng)Ż¼ĮĄĮŌØō─▄▌^┤¾Ż¼└¹ė┌╣żśI(y©©)æ¬(y©®ng)ė├.į┌Š·ųĻ┼ÓB(y©Żng)┴╦15 h║¾Ż¼Š·Ą─ØŌČ╚─▄▀_(d©ó)ĄĮ╝s108 cfu.×ķīŹ(sh©¬)“×(y©żn)ė├Š·╠ß╣®▒ŻūC.
ĪĪĪĪ3.2 ▓╗═¼ĮėĘN┴┐ī”(du©¼)Ę┤æ¬(y©®ng)ę║CODĄ─ė░Ēæ
ĪĪĪĪīóŠ·ųĻųŲ│╔Š·æęę║(108 cfu)Ż¼£y(c©©)Č©▓╗═¼ĮėĘN┴┐ī”(du©¼)25 mg Īż L-1─ŻöMÅU╦«CODĮĄĮŌą¦╣¹Ż¼│§▓ĮĘ┤ė│Š·ę║ųąėąÖC(j©®)╬█╚Š╬’Ą─┴┐Ż¼ĮY(ji©”)╣¹ęŖ(ji©żn)łD 3.

łD3 ĮėĘN┴┐ī”(du©¼)ÅU╦«COD└█ĘeĮĄĮŌ┬╩Ą─ė░Ēæ
ĪĪĪĪÅ─łD 3┐╔ęŖ(ji©żn)Ż¼ļSų°Ģr(sh©¬)ķgį÷ķL(zh©Żng)Ż¼Ę┤æ¬(y©®ng)ę║COD└█ĘeĮĄĮŌ┬╩ųØuį÷┤¾Ż¼ĮėĘNØŌČ╚įĮ┤¾ĮĄĮŌ┬╩įĮĖ▀.7 d║¾ĮĄĮŌ┬╩Ęųäe▀_(d©ó)ĄĮŻ║32.61%;53.79%;62.71%.į┌Ą┌1~2 dĢr(sh©¬)Ż¼Š·ųĻ╔·ķL(zh©Żng)╠Äė┌ī”(du©¼)öĄ(sh©┤)Ų┌Ż¼ĮĄĮŌą¦╣¹║├Ż¼Ę┤æ¬(y©®ng)ę║CODĮĄĮŌ▌^┐ņ.į┌Ą┌3 d║¾╦«ųąCOD└█ĘeĮĄĮŌ┬╩ĘĆ(w©¦n)▓Įį÷╝ėŻ¼Š·ųĻ╔·ķL(zh©Żng)┌ģė┌ĘĆ(w©¦n)Č©.3~7 d COD└█ĘeĮĄĮŌ┬╩ą▒┬╩╗∙▒Šę╗ų┬Ż¼▒Ē├„å╬╬╗Ģr(sh©¬)ķgŠ·¾wĄ─ĮĄĮŌą¦┬╩ĘĆ(w©¦n)Č©.┼cłD 2ųąŠ·ųĻ╔·ķL(zh©Żng)Ū·ŠĆŽÓī”(du©¼)æ¬(y©®ng).šf(shu©Ł)├„L-1Š·ųĻ╔·ķL(zh©Żng)┤·ųxĘĆ(w©¦n)Č©ÅŖ(qi©óng)Ż¼─▄│õĘų└¹ė├ÅU╦«ųąĄ─ėąÖC(j©®)╬’.šf(shu©Ł)├„įōŠ·ųĻ▓ó▓╗─▄čĖ╦┘Ą─īó1Ż¼2Ż¼3Ż¼4-TeCB═Ļ╚½ĄV╗».į┌5 d║¾CODĮĄĮŌ┬╩ųØu£pŠÅŻ¼Ą½─▄▒Ż│ųę╗Č©Ą─ĮĄĮŌą¦╣¹.
ĪĪĪĪ3.3 ▓╗═¼ĮėĘN┴┐ī”(du©¼)┬╚ļxūėßīĘ┼┴┐Ą─ė░Ēæ
ĪĪĪĪį┌┼õųŲ─ŻöMÅU╦«Ģr(sh©¬)Ż¼¤o(w©▓)ÖC(j©®)¹}┼ÓB(y©Żng)╗∙ųą▓╗║¼Cl-Ż¼Ę┤æ¬(y©®ng)ę║ųąĄ─┬╚ļxūė║¼┴┐ČÓ╔┘Ę┤ė│┴╦ĮĄĮŌ▀^(gu©░)│╠ųąī”(du©¼)1Ż¼2Ż¼3Ż¼4-TeCBĄ─ĮĄĮŌ├ō┬╚▀^(gu©░)│╠Ż¼ĮY(ji©”)╣¹ęŖ(ji©żn)łD 4.

łD4 ĮėĘN┴┐ī”(du©¼)┬╚ļxūėßīĘ┼ØŌČ╚Ą─ė░Ēæ
ĪĪĪĪÅ─łD 4┐╔ęį┐┤│÷┬╚ļxūėßīĘ┼ØŌČ╚┌ģä▌(sh©¼)┼cCODĮĄĮŌ│╩ę╗Č©Ą─ŽÓĻP(gu©Īn)ąį.į┌1~4 dŻ¼┬╚ļxūėļSŠ·ØŌČ╚į÷┤¾Ż¼┬╚ļxūėßīĘ┼┴┐ØŌČ╚į÷┤¾.▀@▒Ē├„Š·ųĻį┌1Ż¼2Ż¼3Ż¼4-TeCBĮĄĮŌĄ─▀^(gu©░)│╠ųą┤_īŹ(sh©¬)ėąCl-«a(ch©Żn)╔·.ŪęĮėĘN┴┐įĮ┤¾Ż¼┬╚ļxūėĄ─ßīĘ┼įĮČÓ.Ą½į┌5 d║¾┬╚ļxūėßīĘ┼┴┐Ż¼į┘┤╬│╩¼F(xi©żn)┐ņ╦┘į÷ķL(zh©Żng)Ż¼▒Ē├„įōŠ·ėą┐╔─▄╩╣1Ż¼2Ż¼3Ż¼4-TeCBßīĘ┼ČÓéĆ(g©©)┬╚ļxūėŻ¼┐╔─▄╩╣╚²┬╚╗“š▀Č■┬╚╗»║Ž╬’├ō┬╚.ę“┤╦┬╚ļxūėØŌČ╚Ą─ūāōQ│╩¼F(xi©żn)Č■┤╬į÷ķL(zh©Żng)┌ģä▌(sh©¼).▓╗═¼ĮėĘN┴┐Ę┤æ¬(y©®ng)ę║ųąĄ─┬╚ļxūėØŌČ╚į┌7 dĢr(sh©¬)Ą─║¼┴┐Ęųäe×ķŻ║1.852 mg Īż L-1Ż¼2.742 mg Īż L-1Ż¼4.980 mg Īż L-1.
ĪĪĪĪ3.4 ▓╗═¼ĮėĘN┴┐ī”(du©¼)1Ż¼2Ż¼3Ż¼4-TeCBĄ─ĮĄĮŌ┴┐
ĪĪĪĪÅ─łD 5ųą┐╔ęį┐┤│÷Ż¼1Ż¼2Ż¼3Ż¼4-TeCBĄ─ĮĄĮŌ┴┐ļSų°Ģr(sh©¬)ķgĄ─į÷╝ėČ°į÷┤¾Ż¼│╩¼F(xi©żn)ę╗Č©Ą─Ģr(sh©¬)ķg-ą¦æ¬(y©®ng)ĻP(gu©Īn)ŽĄŻ¼ŪꊷųĻĮėĘN┴┐┤¾ĮĄĮŌ┬╩Ė▀.2%Īó3%Īó5%ĮėĘN┴┐7 d║¾ĮĄĮŌ┴┐┐╔▀_(d©ó)13.74 mg Īż L-1Ż¼14.91 mg Īż L-1Ż¼20.47 mg Īż L-1.Ą┌1~4 dŻ¼▒M╣▄╬ó╔·╬’┴┐į÷ČÓŻ¼Ą½╩ŪŠ·ųĻĮĄĮŌ╦┘┬╩▌^┬²Ż¼▀@┐╔─▄┼cŠ·ųĻ╔ąø](m©”i)ėą║Ž│╔ĮĄĮŌ1Ż¼2Ż¼3Ż¼4-TeCBŽÓæ¬(y©®ng)Ą─├ĖėąĻP(gu©Īn).Ą┌4~6 dŻ¼1Ż¼2Ż¼3Ż¼4-TeCBĄ─ĮĄĮŌ┴┐ųØu╝ė┤¾.▒Ē├„Š·ųĻųØu▀mæ¬(y©®ng)ą┬Ą─├{Ų╚Łh(hu©ón)Š│.ĄĮ7 dĮĄĮŌ┴┐ūā╗»▓╗┤¾Ż¼▒Ē├„Š·ųĻ╔·ķL(zh©Żng)╦∙ąĶėąÖC(j©®)╬’ųØu£p╔┘Ż¼ĮĄĮŌą¦╣¹ę▓ļSų°Ž┬ĮĄ.įōĮY(ji©”)╣¹┼cCOD┴┐ūā╗»▓╗═¼Ż¼Š·ųĻCODį┌Ą┌7 dĢr(sh©¬)ūŅĖ▀ų╗ĮĄĮŌ62%Ż¼▀@▒Ē├„įōŠ·ųĻ─▄└¹ė├1Ż¼2Ż¼3Ż¼4-TeCBŻ¼Ą½ī”(du©¼)1Ż¼2Ż¼3Ż¼4-TeCBĄ─═Ļ╚½ĄV╗»ąĶę¬ę╗éĆ(g©©)▀^(gu©░)│╠Ż¼įōĮY(ji©”)╣¹š²║├┼c┬╚ļxūėĄ─Č■┤╬ßīĘ┼ŽÓ╬Ū║Ž.

łD5 ▓╗═¼ĮėĘN┴┐ī”(du©¼)1Ż¼2Ż¼3Ż¼4-TeCBĮĄĮŌ┴┐
ĪĪĪĪ3.5 ╝ėś╦(bi©Īo)╗ž╩š┬╩┼cRSD║═GC-MS«a(ch©Żn)╬’Ęų╬÷
ĪĪĪĪ▀M(j©¼n)ę╗▓ĮĘų╬÷L-1Š·ųĻī”(du©¼)1Ż¼2Ż¼3Ż¼4-TeCBĄ─ĮĄĮŌ«a(ch©Żn)╬’Ą─╠žąįŻ¼śėŲĘĄ─╝ėś╦(bi©Īo)╗ž╩š┬╩ęŖ(ji©żn)▒Ē 2.

▒Ē2 śėŲĘĄ─╝ėś╦(bi©Īo)╗ž╩š┬╩┼cRSD
ĪĪĪĪ═©▀^(gu©░)ī”(du©¼)Ę┤æ¬(y©®ng)ę║GC-MS£y(c©©)Č©║═Ęų╬÷Ż¼░l(f©Ī)¼F(xi©żn)1Ż¼2Ż¼3Ż¼4-TeCBĮĄĮŌ▀^(gu©░)│╠ųą┤µį┌Ż║2Ż¼3Ż¼4Ż¼5-╦─┬╚-2Ż¼4-╝║Č■Ž®Č■╦ß(A╬’┘|(zh©¼))║═2Ż¼3Ż¼5-╚²┬╚-2Ż¼4-Č■Ž®-1Ż¼4-ā╚(n©©i)§ź-╝║╦ß(B╬’┘|(zh©¼)).łD 6(aĪób)Ęųäe╩ŪAĪóB╬’┘|(zh©¼)Ą─┘|(zh©¼)ūVłD.

łD6 AĪóB╬’┘|(zh©¼)Ą─ŽÓī”(du©¼)žSČ╚
ĪĪĪĪ═©▀^(gu©░)ī”(du©¼)ÅU╦«pHĄ─£y(c©©)Č©Ż¼Ę┤æ¬(y©®ng)ę║Å─pH 7ĮĄĄ═ĄĮpH 5.3Ż¼šf(shu©Ł)├„ūŅĮK«a(ch©Żn)╬’ųą╔·│╔┴╦╦ßąį╬’┘|(zh©¼).═©▀^(gu©░)ī”(du©¼)«a(ch©Żn)╬’Ą─Ęų╬÷Ż¼═Ų£y(c©©)1Ż¼2Ż¼3Ż¼4-TeCBĮĄĮŌ═ŠÅĮ╩ŪŽ╚═©▀^(gu©░)ķ_(k©Īi)Łh(hu©ón)║¾├ō┬╚Ą─═ŠÅĮ.═©▀^(gu©░)ī”(du©¼)ŲõĮĄĮŌ═ŠÅĮĘų╬÷╚ńłD 7╦∙╩Š.

łD7 Š·ųĻL-1ī”(du©¼)1Ż¼2Ż¼3Ż¼4-TeCBĄ─ĮĄĮŌ═ŠÅĮ
ĪĪĪĪ1Ż¼2Ż¼3Ż¼4-TeCBį┌╝ėÜõč§╗»├ĖĄ─ū„ė├Ž┬«a(ch©Żn)╔·Łh(hu©ón)ļpč§╗»Ż¼╔·│╔Łh(hu©ón)┬╚┤·Č■┤╝Ż¼╚╗║¾į┌├ōÜõ├ĖĄ─ū„ė├Ž┬├ō╚źā╔éĆ(g©©)ÜõįŁūė╔·│╔3Ż¼4Ż¼5Ż¼6-╦─┬╚ÓÅ▒ĮČ■Ęė;į┘Įø(j©®ng)▀^(gu©░)č§╗»ķ_(k©Īi)Łh(hu©ón)╔·│╔2Ż¼3Ż¼4Ż¼5-╦─┬╚-2Ż¼4-╝║Č■Ž®Č■╦߯¼▓óį┌ŽÓĻP(gu©Īn)├ĖĄ─ū„ė├Ž┬░l(f©Ī)╔·ā╚(n©©i)§ź╗»├ō╚ź┬╚ļxūė╔·│╔2Ż¼3Ż¼5-╚²┬╚-2Ż¼4-Č■Ž®-1Ż¼4-ā╚(n©©i)§ź-╝║╦߯¼ų«║¾═©▀^(gu©░)╦«ĮŌ├Ė╔·│╔2Ż¼3Ż¼5-Č■┬╚-4-č§┤·-2-Ž®╝║Č■╦߯¼▀@ĘN╗»║Ž╬’─▄į┌NADHū„ė├Ž┬┤“ķ_(k©Īi)ļpµI═¼Ģr(sh©¬)├ō┬╚Ż¼ą╬│╔’¢║═ų¼ĘŠ╦߯¼ūŅ║¾╔·│╔ń·ńĻ╦ß║═ęę╦߯¼ūŅĮK▀M(j©¼n)╚ļTCA裣h(hu©ón).įōųąķg╗»║Ž╬’┤¾▓┐Ęųį┌Ę┤æ¬(y©®ng)ę║ųąÖz£y(c©©)│÷üĒ(l©ói)Ż¼ūCīŹ(sh©¬)┴╦įōĮĄĮŌ═ŠÅĮĄ─┐╔ąąąį╝░įōŠ·ĘN蹊┐Ą─Øōį┌ār(ji©ż)ųĄ.ĻP(gu©Īn)ė┌Š·ųĻL-1Ą─Ųõ╦¹╔·└Ē╔·╗»╠žąį╝░Š·ĘNĶbČ©ųĄĄ├▀M(j©¼n)ę╗▓Į╔Ņ╚ļ蹊┐.Š▀¾wģóęŖ(ji©żn)╬█╦«īÜ╔╠│Ū┘Y┴Ž╗“http://www.dongaorq.cnĖ³ČÓŽÓĻP(gu©Īn)╝╝ąg(sh©┤)╬─ÖnĪŻ
ĪĪĪĪ4 ĮY(ji©”)šō
ĪĪĪĪ1)Å─ÅV¢|─│╗»īW(xu©”)įćä®ÅSų▄▀ģ═┴╚└║Y▀x│÷ę╗ųĻ─▄ĮĄĮŌ1Ż¼2Ż¼3Ż¼4-TeCBĄ─Š·ųĻL-1Ż¼įōŠ·ųĻ×ķČ╠ŚUĀŅŻ¼─▄«a(ch©Żn)╔·č┐░¹Ą─Ė’╠m╩ŽĻ¢(y©óng)ąįŠ·Ż¼Įø(j©®ng)16S rDNAĶbČ©įōŠ·ųĻ×ķ┐▌▓▌č┐µ▀ŚUŠ·.
ĪĪĪĪ2)Š·ųĻL-1▓╗═¼ĮėĘN┴┐ī”(du©¼)─ŻöMÅU╦«(25 mg Īż L-1)Ą─ūŅ╝č╠Ä└Ēą¦╣¹Ż║CODĮĄĮŌ┬╩▀_(d©ó)62.71%Ż¼┬╚ļxūėØŌČ╚▀_(d©ó)4.980 mg Īż L-1;1Ż¼2Ż¼3Ż¼4-TeCBĮĄĮŌ┴┐Ė▀▀_(d©ó)20.47 mg Īż L-1.
ĪĪĪĪ3)ÅU╦«Ą─CODĮĄĮŌ┬╩ļSĮėĘN┴┐į÷┤¾║═ĮėĘNĢr(sh©¬)ķgčėķL(zh©Żng)ųØu╔²Ė▀;1Ż¼2Ż¼3Ż¼4-TeCBĮĄĮŌ▀^(gu©░)│╠ųąėąCl-«a(ch©Żn)╔·Ż¼Ūę│╩¼F(xi©żn)Č■┤╬į÷ķL(zh©Żng)Ą─¼F(xi©żn)Ž¾;Ę┤æ¬(y©®ng)ę║ųą1Ż¼2Ż¼3Ż¼4-TeCBØŌČ╚ļSų°ĮėĘNĢr(sh©¬)ķgųØuĮĄĄ═Ż¼į┌Ą┌7 d 5%ĮėĘN┴┐╠Ä└ĒĮMĄ─ĮĄĮŌ┴┐ūŅ┤¾Ż¼Ė▀▀_(d©ó)20.47 mg Īż L-1Ż¼ūCīŹ(sh©¬)įōL-1Š·ųĻ─▄ē“ĮĄĮŌ1Ż¼2Ż¼3Ż¼4-TeCBŻ¼Ą½Ųõ═Ļ╚½ĄV╗»▀^(gu©░)│╠▒╚▌^Å═(f©┤)ļs.
ĪĪĪĪ4)═©▀^(gu©░)GC-MSĄ╚Ęų╬÷░l(f©Ī)¼F(xi©żn)1Ż¼2Ż¼3Ż¼4-TeCBĄ─ĮĄĮŌ▀^(gu©░)│╠ųą┤µį┌2Ż¼3Ż¼4Ż¼5-╦─┬╚-2Ż¼4-╝║Č■Ž®Č■╦ß║═2Ż¼3Ż¼5-╚²┬╚-2Ż¼4-Č■Ž®-1Ż¼4-ā╚(n©©i)§ź-╝║╦ßā╔ĘNĻP(gu©Īn)µI╬’┘|(zh©¼).═Ų£y(c©©)ŲõĮĄĮŌ▀^(gu©░)│╠╩ŪŽ╚ķ_(k©Īi)Łh(hu©ón)║¾├ō┬╚.


